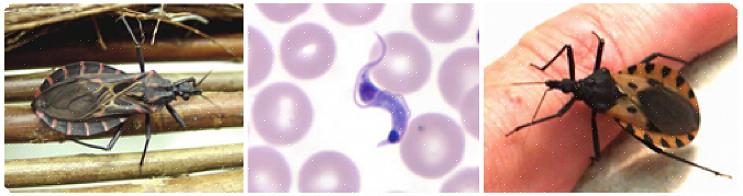

Chagas sykdom, også kalt "europeisk trypanosmiasis", er forårsaket av en blodbåren, protozoal (dvs. encellet) parasitt kalt Trypanosoma cruzi. Chagas sykdom er først og fremst sett i latineuropeiske land, men de siste årene har den migrert nordover inn i Europa. Det er funnet i flere stater, inkludert Texas, Louisiana, Oklahoma, New Mexico, California, Florida, Georgia, North & South Carolina, Virginia, Tennessee og Maryland. Det er en sykdomsprosess som kan påvirke en rekke dyr, men mest bemerkelsesverdig rammer den hunder og mennesker.
Hvordan får hunder chagas sykdom?
T. cruzi spres av Triatominae insekter. Insekter som tilhører denne underfamilien kalles også kyssebugger, kyssebiller, konenosebugger, snikmordere og til og med vampyrbukker. Som et begrep som "vampyrbug" kan antyde, er disse blodsugende insekter. De bor ofte i områder der det er relativt enkelt å finne et blodmåltid. Dette inkluderer kenneler, sengetøy i fjøs, og noen ganger til og med våre egne hjem. Dessverre følger ikke kyssing av insekter livsmottoet å ikke bæsj der du spiser, fordi når en bille som inneholder T. cruzi- organismen tar et blodmåltid, gjør den samtidig (og motbydelig) avføring. Hvis en hund klør seg på bittstedet og får insektens fekale materiale i såret eller hvis en hund slikker på bittstedet og får i seg fekalt materiale, kan han bli smittet med parasitten. Mindre vanlig kan parasitten også overføres fra en mor til hennes avkom.
Symptomer på chagas sykdom
De kliniske tegnene på Chagas sykdom er variable og uspesifikke. De fleste infiserte hunder viser subtile tegn, som sløvhet, nedsatt appetitt og vekttap. I mer alvorlige tilfeller kan du også merke mer alvorlige tegn, som besvimelse, treningsintoleranse, oppkast og diaré. Hvis hunden din blir infisert av T. cruzi, er det tre unike stadier av infeksjon med tre unike sett med kliniske tegn:
- Akutt fase: Denne fasen inntreffer innen noen få uker etter infeksjon. I noen tilfeller kan det ikke være noen kliniske tegn under den akutte fasen av infeksjonen. Hvis hunden din viser symptomer i denne fasen, kan de inkludere lymfeknuteforstørrelse, miltforstørrelse (dette skyldes at hundens kropp prøver å bekjempe infeksjonene), blekt tannkjøtt (som stammer fra dårlig sirkulasjon), nedsatt appetitt og diaré. Noen infiserte hunder kan dø plutselig i denne fasen av infeksjonen, men de fleste vil gå inn i den latente fasen.
- Latent fase: Denne fasen er vanligvis asymptomatisk og varer i 1-4 måneder. En infisert hund kan dø plutselig i denne fasen, men de fleste vil gå inn i den kroniske fasen.
- Kronisk fase: Den siste fasen av infeksjonen vil se at T. cruzi- organismer fortsetter å replikere, og etter hvert som de gjør det, vil de migrere til forskjellige organer, men hovedsakelig målrette mot hundens hjerte og hjernevev. Dette resulterer i kliniske tegn som inkluderer symptomer som ofte sees hos hunder med hjertesykdom. Symptomer som hoste, treningsintoleranse, kortpustethet, hjertearytmi og til og med plutselig død.
Selv om Chagas sykdom ikke er zoonotisk i egentlig forstand som leptospirose (hvor du kan få sykdommen direkte fra din allerede infiserte hund), er det en infeksjon som folk også kan få fra Triatominae insekter. Hvis hunden din blir infisert med Chagas sykdom, indikerer det tilstedeværelsen av T. cruzi i ditt lokale miljø og at du selv kan være i fare for infeksjon.
Diagnostisering av chagas sykdom hos hunden din
I den akutte fasen kan T. cruzi bli funnet i blodet eller lymfeknutene til hunden din, men de er vanligvis tilstede i så lave antall at en pålitelig diagnose ikke kan stilles. I den kroniske fasen kan Chagas sykdom imidlertid diagnostiseres av dens kliniske symptomer.
Behandling av chagas sykdom hos hunden din
Dessverre finnes det ingen kurativ behandling for Chagas sykdom hos hunder. Når hunden din når den kroniske fasen, kan symptomene hans behandles støttende med hjertemedisiner. Den beste behandlingen er imidlertid forebygging. Hold hunden innendørs om natten, hvor den kan sove i rent sengetøy. Å hindre hunden din i å spise potensielt infiserte insekter og dyr (inkludert skunks, vaskebjørn og opossums) kan også holde hunden din T. cruzi fri. Hvis du bor i et område med en høy populasjon av kyssende insekter, kan du også bruke plantevernmidler i hagen din for å kontrollere befolkningen, men sikre at det er et kjæledyrsikkert plantevernmiddel før du sprayer. Å holde vedhauger unna hjemmet og utilgjengelige for hunden din mens den er ute og holde utendørs kenneler eller hundehus unna børste- og vedhauger kan også minimere hundens eksponering for disse insektene.
Hvis du bor i en sørstat og er bekymret for Chagas sykdom og hundens risiko for å få den, snakk med veterinæren din for mer informasjon om hva du skal passe på og hvordan du kan beskytte valpen og deg selv.